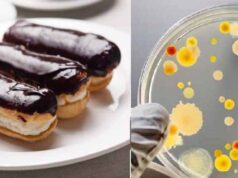
Закрили кав’ярню “Наше місто”, в якій 5 людей заразилися сальмонельозом Закрили кав’ярню "Наше місто"

Правоохоронці закрили замовну кримінальну справу проти профспілки «Захист праці»
Нарешті скінчилася епопея замовної кримінальної справи проти профспілкової організації «Захист праці».
Нагадаю, майже рік тому правоохоронцями Нововолинського відділку поліції за заявою директора ДП Шахта...
На шахті №9 представлять нового керівника, колектив проти!
18-го липня на шахті №9 “Нововолинська” відбудеться представлення нового керівника копальні – екс-директора ДП “Волиньвугілля” Михайла Гарбузюка. Про це інтернет-видання “БУГ” повідомив лідер...
На дорогу до Володимира витратять ще 110 мільйонів гривень
Дорога від Володимира до Нововолинська (Р-15 Ковель - Жовква) очікує ремонту. Про це стало відомо зі слів першого заступника голови Волинської ОДА Олександра Степанцова.Загальна...
Почесний громадянин міста: Лєйкіна – не чіпати, а Байдовський – “не на часі”
У міськраді вважають недоцільним позбавлення звання «Почесний громадянин міста Нововолинська» колишнього начальника відділу освіти (покійного) Михайла Лєйкіна, натомість не хочуть присвоїти звання «Почесний громадянин...
Пограбували колишнього селищного голову
Серед білого дня, близько 7 години, грабіжники вдерлися у хату колишнього селищного голови -Володимира Рудя. Залізли, схоже, через вікно, так як воно було поламане,...
Над Нововолинськом пролетів торнадо! (Оновлено)
"На фото його ледве помітно, але насправді він був більш контрастним (трубу було помітно над хрестом цегляної церкви сьогодні біля 16:00)", - написав у...
Нововолинці – за здоровий спосіб життя!
Є у Нововолинську люди, які сповідують здоровий образ життя. Їхній тренер Сергій Смолярук, або Smol, регулярно запрошує всіх на ранкову пробіжку. Збір о 6:00 кожної...
Польський телеканал проілюстрував “геноцид поляків” знімком українських жертв. 18+
Польський телеканал "Хісторія" проілюстрував допис про польських жертв УПА фотографією вбитих українців.
11 липня в Польщі вперше відзначали "Національний день пам’яті жертв геноициду громадян Другої...
На Волині викрито організовану злочинну групу, яка за сприяння корумпованих митників незаконно ввозила в...
Прокуратурою Волинської області спільно з Управлінням захисту економіки в області департаменту захисту економіки Національної поліції України у ході розслідування фактів протиправного ввезення на митну...
Про «таємниці» острова у Світязі відзняли відео
У мережі з'явився трейлер фільму жахів про острів на озері Світязь, - пише Район.ШацькКористувач Dooomaniya виклав не без гумору відзняте відео в YouTube під...
Як волинянам знайти інформацію про своїх предків
В сучасних умовах вільного доступу до інформації, кожен охочий може розпочати генеалогічні пошуки, не виходячи із дому. Світові інформаційні ресурси сьогодні є найпопулярнішим джерелом...
#позбавлення недоторканності: як голосував нардеп Ігор Гузь
Цього тижня у Генпрокурор України Юрій Луценко вніс шість (!) подань до Верховної Ради України щодо надання згоди на притягнення до кримінальної відповідальності народних...
На Західній Україні розшукують грабіжника, який спеціалізується на дітях!
На території Тернопільської області зареєстровано вже кілька випадків пограбування зловмисником дітей, у яких він забирає гроші і цінні речі. Рятуючись від переслідування правоохоронців зловмисник...
Кінотеатр “Україна” пішов з молотка за чотири з половиною мільйони гривень
14-го липня на аукціоні, який відбувся у приміщенні Нововолинської ради, кінотеатр “Україна” купив місцевий підприємець Юрій Сиротюк за 4 мільйони 692 тисячі гривень.
Cтартова ціна продажу становила...
Нововолинськ отримає 1.2 млн гривень на капремонт операційної та садочків
Кабінет Міністрів України виділив на розвиток міста Нововолинськ – 1,2 мільйони гривень. Ігор Гузь стверджує, що гроші для міста виділяються саме на його прохання. Із...
Звернення Первинної профспілкової організації “Захист Праці” на ДП Шахта №1 “Нововолинська” щодо незаконного переслідування...
«Завтра це вигадане правове беззаконня може бути застосований проти кожного з нас. Тому ми сьогодні повинні стати на захист
Богдана Макарчука».
Первинна профспілка «Захист...
Закрили кав’ярню “Наше місто”, в якій 5 людей заразилися сальмонельозом
Кав'ярня, в якій п'ятеро людей «підхопили» сальмонельоз, наразі не працює.
Про це інформує прес-служба Волинського обласного лабораторного центру.
П’ятеро осіб, в тому числі троє дітей 3,8 і 13 років...
Нечистоти біля 2 шахти зливає… водоканал!
Труба, з якої наподалік села Морозовичі гримуча суміш витікає просто в ґрунт, належить підприємству “Нововолинськводоканал”.
На околиці Нововолинська, в районі шахти №2, неочищені стоки зливаються просто...
У Нововолинську закрили гральний заклад
Володимир-Волинська місцева прокуратура здійснює процесуальне керівництво досудовим розслідуванням у кримінальному провадженні за фактом незаконного заняття гральним бізнесом (кримінальне правопорушення, передбачене ч.1 ст. 203-2 КК України). Про це повідомляє прокуратура...
Вибух, який чули у Нововолинську, пролунав від пробивання звукового бар’єру винищувачем
Близько години тому пролунав "вибух", який чули у Нововолинську та Володимирі-Волинському.У МНС пояснили, що над військовим полігоном у Володимирі-Волинському летів літак на низькій висоті,...